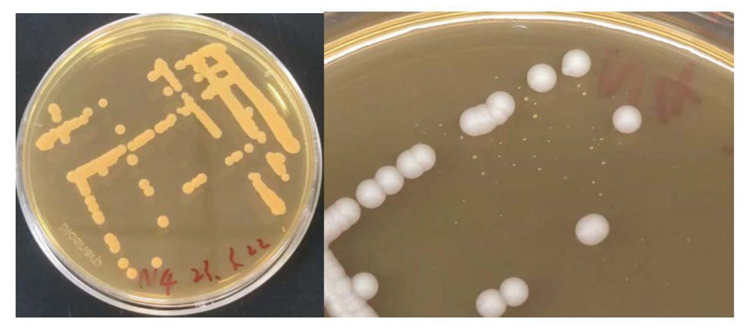

随着畜禽养殖集约化发展,养殖舍产生的氨气、硫化氢及挥发性有机物(VOCs)等臭气污染问题日益突出,严重制约产业绿色可持续发展。传统喷淋净化装置依赖连续喷淋,耗水量大、耗电高、运行成本居高不下,亟须创新解决方案。
近期,国家生猪技术创新中心养殖环境与工程研究院成功研发出一种节能型畜禽养殖舍净化装置,并同步开发了配套的气体净化用微生物菌株和过滤层填料,通过特殊的过滤结构和间歇性喷淋方法实现对规模场畜禽养殖舍臭气的节水节能净化。其中二级过滤层采用改性聚氨酯海绵填料球体,负载改性活性炭/沸石粉及专利菌株(贝莱斯芽孢杆菌N4),显著提升臭气吸附处理能力,氨气去除率达95%;采用“间歇喷淋”运行模式,较传统连续喷淋模式节水90%以上,节电80%以上。在猪场现场中试试验表明:臭气浓度从处理前的平均332(无量纲)降至<10,氨气平均去除率为72.45%。
该技术体系有效解决了传统养殖场臭气净化装置水电消耗巨大的行业难题,显著提升了净化效率和运行经济性,为畜禽养殖业的绿色低碳发展和“双碳”目标实现提供了强有力的技术支撑,具有广阔的市场推广前景。
本研究得到国家生猪技术创新中心先导科技项目(NCTIP-XD/B07)支持,研究成果获授权国家发明专利1项并牵头制定了行业标准《滴滤式畜禽舍废气净化设备》1项,对畜禽养殖废气治理的标准化、高效化具有重要的推动作用。
图 1 贝莱斯芽孢杆菌 N4 菌落形态
图 1 贝莱斯芽孢杆菌 N4 菌落形态


图 2 竖流及横流式净化装置
图3 行业标准立项通知










